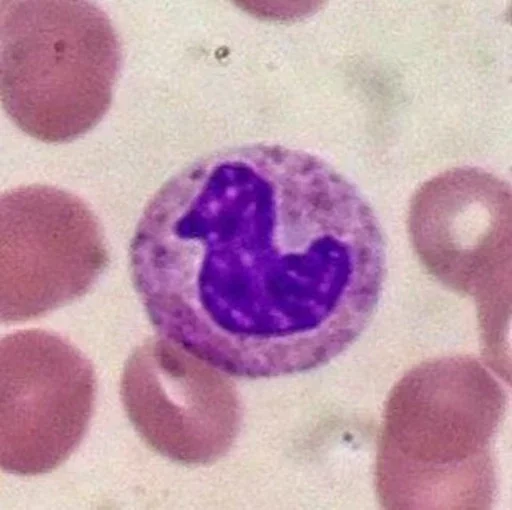

Набор стикеров «Blood mood»

Стикеры телеграм «Blood mood» (BloodMoodEosenophiles) добавлен в нашу базу 01.10.2025 11:40.
Стикерпак содержит 7 статичных (не анимированных) стикеров.
Набор Telegram стикеров «Blood mood» доступен по постоянной ссылке t.me/addstickers/BloodMoodEosenophiles.
Стикерпак содержит 7 статичных (не анимированных) стикеров.
Набор Telegram стикеров «Blood mood» доступен по постоянной ссылке t.me/addstickers/BloodMoodEosenophiles.
❗ Если этот набор стикеров нарушает правила или содержит запрещённый контент — сообщите нам.













